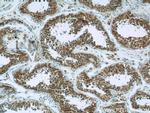
Hexokinase 1 Antibody in Immunohistochemistry (Paraffin) (IHC (P))

Search
Proteintech
Hexokinase 1 Polyclonal Antibody
{{$productOrderCtrl.translations['antibody.pdp.commerceCard.promotion.promotions']}}
{{$productOrderCtrl.translations['antibody.pdp.commerceCard.promotion.viewpromo']}}
{{$productOrderCtrl.translations['antibody.pdp.commerceCard.promotion.promocode']}}: {{promo.promoCode}} {{promo.promoTitle}} {{promo.promoDescription}}. {{$productOrderCtrl.translations['antibody.pdp.commerceCard.promotion.learnmore']}}
产品信息
19662-1-AP
种属反应
已发表种属
宿主/亚型
分类
类型
抗原
偶联物
形式
浓度
规格
纯化类型
保存液
内含物
保存条件
运输条件
产品详细信息
Immunogen sequence: SDFLDYMGI KGPRMPLGFT FSFPCQQTSL DAGILITWTK GFKATDCVGH DVVTLLRDAI KRREEFDLDV VAVVNDTVGT MMTCAYEEPT CEVGLIVGTG SNACYMEEMK NVEMVEGDQG QMCINMEWGA FGDNGCLDDI RTHYDRLVDE YSLNAGKQRY EKMISGMYLG EIVRNILIDF TKKGFLFRGQ ISETLKTRGI FETKFLSQIE SDRLALLQVR AILQQLGLNS TCDDSILVKT VCGVVSRRAA QLCGAGMAAV VDKIRENRGL DRLNVTVGVD GTLYKLHPHF SRIMHQTVKE LSPKCNVSFL LSEDGSGKGA ALITAVGVRL RTEASS (583-917 aa encoded by BC008730)
靶标信息
This gene encodes a member of the ARHGAP family of Rho/Rac/Cdc42-like GTPase activating proteins. The encoded protein interacts with the Ras-related protein Gem through its N-terminal domain. Separately, it interacts with RhoA through a RhoGAP domain, and stimulates RhoA-dependent GTPase activity. Alternatively spliced variants that encode different protein isoforms have been described but their full-length nature has not been determined.
仅用于科研。不用于诊断过程。未经明确授权不得转售。
生物信息学
蛋白别名: Brain form hexokinase; CNSHA5; downeast anemia; glycolytic enzyme; hexokinase; hexokinase IR; Hexokinase type I; Hexokinase, tumor isozyme; Hexokinase-1; Hexokinase-A; HK; HK I; HK1-ta; HK1-tb; HK1-tc; HK1-td; HKD; HKI; HMSNR; HXK1; NEDVIBA; Neuropathy, hereditary motor and sensory, Russe type; NMSR; RP79; unnamed protein product
基因别名: BB404130; CNSHA5; dea; HEXOKIN; hexokinase; HK; Hk-1; HK1; Hk1-s; HK1-ta; HK1-tb; HK1-tc; HKD; HKI; HMSNR; HXK1; mHk1-s; NEDVIBA; NMSR; RP79
UniProt ID: (Human) P19367, (Rat) P05708, (Mouse) P17710
Entrez Gene ID: (Human) 3098, (Rat) 25058, (Mouse) 15275